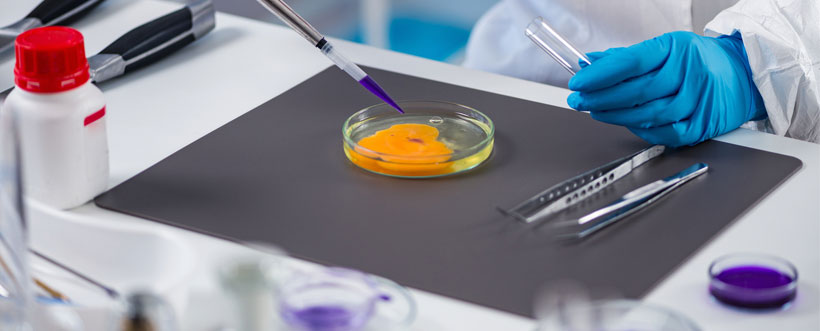
BRC Versión 8

APPCC. 10 cosas que debes recordar en el análisis de peligros
APPCC
El Análisis de Peligros y Puntos de Control (APPCC) es un instrumento que faculta la posibilidad de realizar evaluaciones de peligros y crear un sistema de control ajustado de tal forma que permita la prevención. Se puede aplicar en toda la cadena alimentaria, desde la elaboración y fabricación, incluyendo la transformación, envasado, almacenamiento, transporte, distribución y manipulación, hasta la fase final que corresponde con la venta al consumidor, fuente Anexo al CAC/RCP-1 (1969), Rev. 4 (2003).